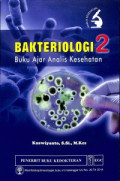
cover

Bakteriologi 2 : Buku Ajar Analis Kesehatan
Buku ini lebih khusus membahas berbagai bakteri enterik dan selaput lendir yang lazim kita jumpai dalam kehidupan sehari-hari. Dalam setiap spesies bakteri dijelaskan berbagai hal, termasuk klasifi…
- Edisi
- -
- ISBN/ISSN
- 978-979-044-713-4
- Deskripsi Fisik
- x, 130 hlm. ; 16 x 24 cm.
- Judul Seri
- -
- No. Panggil
- 616.920 1 KUS b

Bakteriologi 1 : Buku Ajar Analis Kesehatan
Bakteriologi adalah ilmu yang mempelajari tentang sejarah, seluk beluk, tinjauan klinis/patologis, epidemiologi, dan teknik diagnosis bakteri dari segala aspek, baik klinis, standar laboratorium, m…
- Edisi
- -
- ISBN/ISSN
- 978-979-044-608-3
- Deskripsi Fisik
- xi, 146 hlm ; 15,5 x 24 cm;
- Judul Seri
- -
- No. Panggil
- 616.920 1 KUS b

Bakteriologi 3 : Buku Ajar Analis Kesehatan
Bakteriologi adalah ilmu yang mempelajari tentang sejarah, seluk beluk, tinjauan klinis/patologis, epidemiologi, dan teknik diagnosis bakteri dari segala aspek, baik klinis, standar laboratorium, m…
- Edisi
- -
- ISBN/ISSN
- 978-979-044-791-2
- Deskripsi Fisik
- xii, 134 hal.; ilus.; 24 cm.
- Judul Seri
- -
- No. Panggil
- 616.920 1 KUS b
Hasil Pencarian
Ditemukan 3 dari pencarian Anda melalui kata kunci: Pengarang : "Kuswiyanto, S.Si., M.Kes"
Permintaan membutuhkan 0.00043 detik untuk selesai

Karya Umum
Karya Umum  Filsafat
Filsafat  Agama
Agama  Ilmu-ilmu Sosial
Ilmu-ilmu Sosial  Bahasa
Bahasa  Ilmu-ilmu Murni
Ilmu-ilmu Murni  Ilmu-ilmu Terapan
Ilmu-ilmu Terapan  Kesenian, Hiburan, dan Olahraga
Kesenian, Hiburan, dan Olahraga  Kesusastraan
Kesusastraan  Geografi dan Sejarah
Geografi dan Sejarah